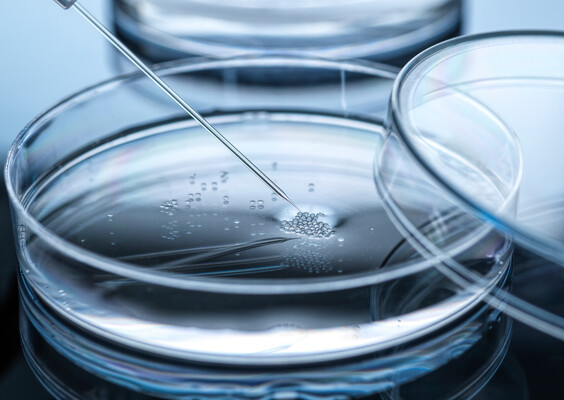

Bio-Engineered Bacteria for Cancer Therapy
- Field
- Therapeutic Biologics
- Patent
- IP00422
Key Problem and Market Opportunity
- Cancer is one of the top killers in the world. The issue of resistance to conventional anticancer treatments in patients has prompted the need to explore alternative therapeutic strategies. The challenge is to identify a therapy which is selective for tumors with limited toxicity to normal tissue.
- Engineered bacteria may have the potential to overcome traditional therapies’ limitations by targeting tumors. However, bio-safety of the bacterial therapy is a big concern.
- According to transparency Market Research, the global anticancer drugs market was valued at US$ 85.0 Bn in 2016 and is projected to expand at a CAGR of about 6 to 7% from 2017 to 2025 to reach US$ 155.6 Bn in 2025.
Key Advantages of the Technology
Using an advanced DNA engineering method of recombineering and the concept of synthetic biology, the investigators successfully converted Salmonella typhimurium into an “obligate” anaerobe, namely YB1.
Key Features of YB1:
- Increased bio-safety (minimal damage to aerobic normal tissues)
- Tumor targeting and direct lysis of tumor cells
- Stimulates the overall immune response to increase the effectiveness of tumor treatment
YB1 treatment outcomes on mice:
- Breast cancer: tumor growth reduced by 50% and cancer metastasis completely inhibited ().
- Liver cancer: tumor growth remarkably suppressed by 90% ().
- The growth of other solid tumors, for example, neuroblastoma, were also inhibited.
Upgraded versions of YB1:
- YB1 can be used as a delivery vector and equipped with different therapeutic drugs to further improve the therapeutic outcome.
- An upgraded version of YB1 (YB1 carrying Diphtheria toxin A) not only completely suppressed breast tumor growth but also reduced tumor size by inducing cancer cell death.
Potential Product and Services
- Anti-cancer therapy with genetic modified bacteria
Development Status and IP Strength
Stage of Development
Engineered salmonella strain YB1 have been tested in laboratory animals and pets (including cats and dogs) for its efficacy, safety and potency.
Patents
- US Patent No. 9,127,284 issued on 8 Sep 2015
- CN Patent No. ZL201380023412.0 issued on 27 Oct 2017
- EP Patent No. 2844736 issued on 1 Mar 2017
- US Patent Application No. 14/019,058 filed on 5 Sep 2013
IP Status
- Patented